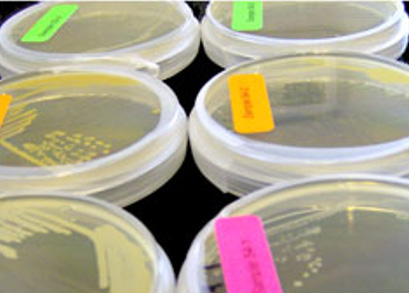
USP 51美国药典 抗菌药物有效性测试

USP 51美国药典 抗菌药物有效性测试

USP 51美国药典 抗菌药物有效性测试
USP <51>《抗微生物效力试验》(Antimicrobial Effectiveness Testing)是美国药典中用于评价药品或化妆品中防腐体系有效性的方法。其目的是验证制剂在储存和使用过程中能否抑制或杀灭潜在的微生物污染,从而确保产品的安全性和稳定性。防腐剂功效测试,通常被称为防腐剂功效测试 (PET)、抗菌剂功效测试 (AET) 或防腐剂挑战测试。
USP <51> 适用于评估含有防腐剂(preservatives)的多剂量制剂(multi-dose products)或其他可能在使用过程中暴露于微生物污染的非无菌药品、化妆品或生物制品的抗菌防腐效果。适用产品类型:
- 非无菌水性制剂(aqueous products)
- 多次启封使用的制剂(multi-dose formulations)
- 外用、口服、眼用、耳用、鼻用等药物制剂
- 化妆品及个人护理产品(如乳液、霜剂、凝胶)

USP <51>防腐剂功效测试
在进行防腐剂效力测试之前,产品需首先进行细菌、酵母和霉菌的检测,以确认其无菌性。如果样品中存在微生物,我们将确定这些微生物是否会影响产品的防腐效果,并依据美国药典 USP <51> 的标准进行防腐剂效力测试。根据初步的无菌检测结果,产品会接种美国药典(USP)推荐的特定细菌、酵母和霉菌菌株,包括:
⬤ 金黄色葡萄球菌(细菌)
⬤ 大肠杆菌(细菌)
⬤ 铜绿假单胞菌(细菌)
⬤ 白色念珠菌(酵母)
⬤ 巴西曲霉(霉菌)

在测试过程中,将已知数量的这些标准菌种接种到产品中,以评估防腐体系的有效性。然后分别在第 0、7、14 和 28 天取样检测,记录微生物数量的变化情况。
通过分析不同时期的结果,可判断产品防腐体系对微生物的抑制或杀灭能力,从而验证其防腐效果是否符合 USP <51> 的要求。
USP <51>防腐剂功效测试---判断依据
根据结果,可将产品分为四个类别:
(1)第一类产品:
注射剂;其他注射用制剂(包括乳剂)、滴耳剂、无菌鼻用制剂及眼用制剂;以及以水性基质或载体制成的产品。要求:
⬤ Bacteria(细菌):
第7天至少减少1.0 log,第14天至少减少3.0 log,第28天不得比14天时增加
⬤ Yeast & Molds(酵母与霉菌):
第7、14、28天都不得比初始值增加
(2)第二类产品:
包括以水性基质或载体制成的局部用药产品;非无菌鼻腔产品和乳剂,包括用于粘膜的产品和乳剂。要求:
⬤ Bacteria(细菌):
第14天至少减少2.0 log,第28天不得比14天时增加
⬤ Yeast & Molds(酵母与霉菌):
第14、28天都不得比初始值增加
(3)第三类产品:
除抗酸剂以外的口服产品,以水性基质或载体制成。要求:
⬤ Bacteria(细菌):
第14天至少减少1.0 log
⬤ Yeast & Molds(酵母与霉菌):
第14、28天都不得比初始值增加
(4)第四类产品:
以水为基质的抗酸剂。要求:在第14、28天都不得比初始值增加(Bacteria细菌、Yeast酵母和 Molds霉菌)
赛德斯威(SATISFY)专注于化妆品检测与法规研究。服务覆盖美国、加拿大、欧盟、澳大利亚、东盟、中国等全球主要市场,提供各国及地区化妆品功效评估、法规咨询、安全评估与检测服务。更多信息请联系赛德斯威客服获取专业指导与一站式检测认证支持。
